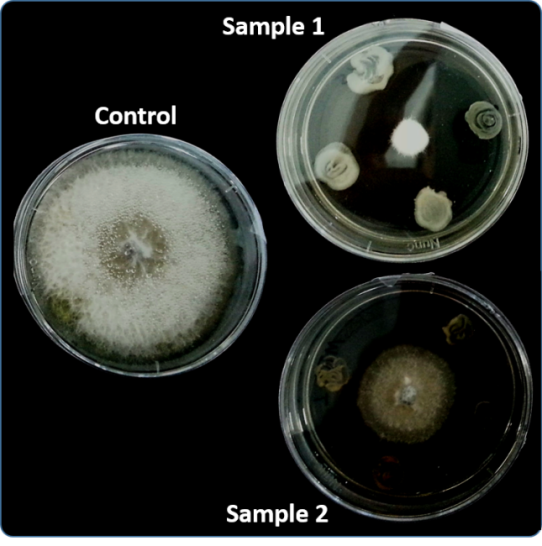

Υπερβακτήριο… βαμπίρ βρέθηκε στους πάγους της Ρουμανίας – Ανατρέπει όσα γνωρίζαμε για τα αντιβιοτικά
Ένα εντυπωσιακό επιστημονικό εύρημα από τα βάθη παγωμένου σπηλαίου στη Ρουμανία έρχεται να ανατρέψει βασικές παραδοχές γύρω από ένα από τα μεγαλύτερα προβλήματα της σύγχρονης ιατρικής: την αντοχή στα αντιβιοτικά. Ερευνητές κατάφεραν να απομονώσουν ένα βακτήριο που παρέμεινε εγκλωβισμένο σε στρώματα πάγου για περίπου 5.000 χρόνια, πολύ πριν την ανακάλυψη και χρήση των αντιβιοτικών από […]